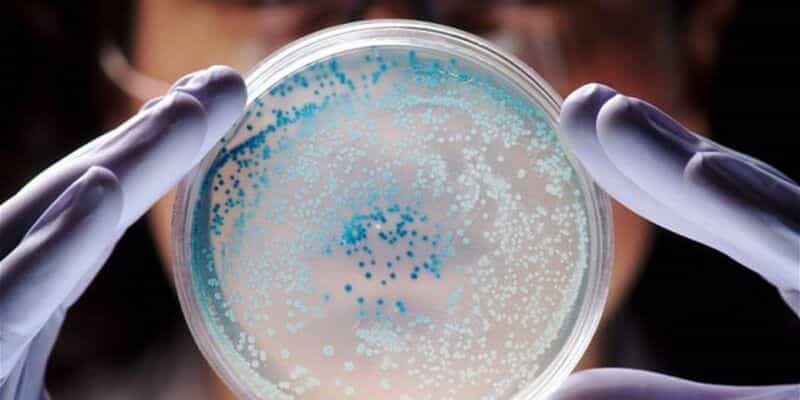

O μύκητας που απειλεί πλέον εκατομμύρια ανθρώπους λόγω υπερθέρμανσης του πλανήτη

Σύμφωνα με νέες μελέτες ένας θανατηφόρος μύκητας προκαλεί ανθεκτικές λοιμώξεις και αποτελεί απειλή για την ανθρώπινη υγεία και την επισιτιστική ασφάλεια. Πιο συγκεκριμένα καταγράφονται σοβαρές απειλές από τον ασπέργιλλο, ο οποίος είναι ένας μύκητας που προκαλεί ανθεκτικές λοιμώξεις ενώ παράλληλα επιδεινώνεται το φαινόμενο της κλιματικής αλλαγής. Η αύξηση της θερμοκρασίας στον πλανήτη επιταχύνει την εξάπλωσή […]
The post O μύκητας που απειλεί πλέον εκατομμύρια ανθρώπους λόγω υπερθέρμανσης του πλανήτη appeared first on Techmaniacs.
Μετάβαση στην Πηγή
Author: Χρήστος Ζλάτης
Πως σας φάνηκε το αρθρο?
ΑΠΙΘΑΝΟ
0
ΚΑΛΟ
0
ΜΕ ΑΡΕΣΕ
0
ΟΚ ΔΕΝ ΤΡΕΛΑΘΗΚΑ
0
ΧΑΧΑ ΕΛΑ ΠΛΑΚΑ ΚΑΝΕΙΣ
0